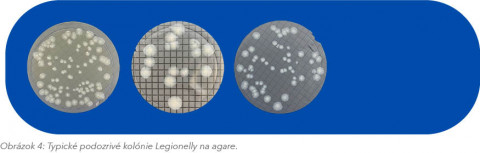

LEGIONELLA Vo vodách. Prečo je testovanie dôležité?!?!
Vydáva: December 2023
Stiahnuť PDF
EnviroMail_11_Európa_Legionella vo vodách
Aj keď je ochorenie spôsobené baktériou Legionella relatívne vzácne, je nevyhnutné pravidelne kontrolovať a analyzovať prítomnosť tejto baktérie vo vodách, najmä s ohľadom na ochranu verejného zdravia, zaistenie bezpečného pracovného prostredia, dodržiavanie predpisov a prevenciu ekonomických a sociálnych dopadov, spojených s výskytom tohto ochorenia. Pravidelný monitoring vôd, údržba a vhodné opatrenia kontroly sú kľúčové pre komplexný systém sledovania výskytu baktérií Legionella.
Čo presně je Legionella?
Legionella je baktéria, ktorá sa prirodzene vyskytuje vo vodnom prostredí. Legionella môže byť v nízkych koncentráciách nájdená nielen v prírodných sladkovodných vodách, vrátane povrchových vôd (jazerá, potoky), ale aj v podzemných vodách. Táto nebezpečná baktéria je často nachádzaná v vodných systémoch budov, ako sú napríklad chladiace veže alebo kondenzátory (v rámci veľkých klimatizačných systémov), ale tiež v okrasných vodných prvkoch (fontány, jazierka), zberných systémoch dažďovej vody, alebo v nedostatočne udržiavaných vírivkách a kúpeľoch.

V takýchto systémoch s teplou stojatou vodou (25 – 42 °C) a usadenými zvyškami má Legionella optimálne podmienky na rozmnožovanie. Pri teplotách nižších ako 20 °C sa baktéria už nedokáže množiť a prechádza do stavu pokoja. Keďže baktéria Legionella je prirodzene prítomná vo vodnom prostredí, nemožno ju nikdy úplne zničiť, ale jej rast možno kontrolovať. Legionella je schopná rýchleho množenia, svoj počet dokáže zdvojnásobiť už za 4 hodiny. To znamená, že jeden mikroorganizmus môže v priebehu 24 hodín vyprodukovať až 64 jedincov. Za týždeň môže tento počet dosiahnuť závratných 4,4*10¹² jedincov. Z týchto dôvodov je nevyhnutné monitorovať a regulovať teplotu vodných systémov, zabezpečiť dostatočný prietok vody a minimalizovať podmienky vhodné na množenie Legionelly.
Medzi najúčinnejšie opatrenia, ktoré môžu znížiť výskyt infekcií spôsobených baktériou Legionella, sú opatrenia na obmedzenie rastu baktérií vo vodovodných systémoch budov a zároveň minimalizovanie expozície ľudí. Regulácia teploty, zabránenie hromadeniu stojacej vody, používanie vhodných dezinfekčných postupov, pravidelná údržba a monitorovanie vodných systémov zvyčajne účinne eliminujú výskyt tejto baktérie.
Prečo je testovanie Legionelly dôležité?
Legionella pneumophila spôsobuje Legionársku chorobu, závažné a potenciálne smrteľné ochorenie dýchacích ciest, ktoré vedie k ťažkému zápalu pľúc. Baktéria môže spôsobiť aj miernejšie ochorenie nazývané Pontiacka horúčka, vyvolávajúce príznaky podobné chrípke, ktoré zvyčajne spontánne ustúpia bez liečby v priebehu niekoľkých dní. Tieto ochorenia sú spôsobené vdýchnutím aerosólov alebo kvapôčok vody kontaminovaných baktériou Legionella; ochorenia sa neprenášajú medzi ľuďmi.
Pravidelné monitorovanie Legionelly a vhodné kontrolné opatrenia môžu zabrániť Legionárskej chorobe. Pravidelné monitorovanie by sa malo vykonávať v turistických ubytovacích zariadeniach, nemocniciach, zariadeniach dlhodobej starostlivosti alebo iných zariadeniach, kde prítomnosť baktérie môže predstavovať nebezpečenstvo pre väčší počet ľudí, ktorí môžu byť náchylnejší na riziko vdýchnutia aerosólov obsahujúcich baktériu.
Podmienky vhodné pre Legionellu?
- Voda: Teplota vody je udržována v rozsahu 20–42°C; obsahuje vhodné živity a je stojatá.
- Zdroje: Ohrievače vody (kaloriféry); postrekovače, chladiace veže; klimatizačné zariadenia; vírivky;
vodoliečebné vane; sprchy; domáce vodovodné systémy; slepé potrubia.

Legislatíva: Regulačné požiadavky EÚ
Vzhľadom na rýchly nárast prípadov legionelózy v posledných rokoch EÚ začlenila kontrolu Legionelly do smernice EÚ 2020/2184. Táto smernica zahŕňa stanovenie koncentrácie Legionelly medzi parametre, ktoré sa majú hodnotiť pri určovaní kvality pitnej vody určenej na ľudskú spotrebu. Uvedené nariadenie bolo rozšírené aj na monitorovanie Legionelly vo všetkých distribučných systémoch pitnej vody vrátane veľkých domácich vodovodných systémov a priemyselných distribučných systémov.
Limit pro Legionella spp. bol stanoven na 1000 CFU/L. Je dôležité zdôrazniť, že smernica EÚ vyžaduje testovanie všetkých Legionella spp., nielen Legionella pneumophila.
Pravidelné kontroly sú dôležité!
Pravidelné kontroly na prítomnosť baktérií Legionella a vhodné kontrolné opatrenia môžu zabrániť prípadom Legionárskej choroby v ubytovacích zariadeniach, nemocniciach, zariadeniach dlhodobej starostlivosti alebo na iných miestach, kde by mohlo byť ochoreniu vystavené väčšie množstvo ľudí.
Odporúčané opatrenia zahŕňajú:
- Zabezpečenie pravidelnej údržby, čistenia a dezinfekcie vodných systémov vrátane potrubných systémov, chladiacich veží, víriviek a dekoratívnych fontán.
- Udržiavanie systémov studenej vody pod 20 °C a systémov teplej vody nad 50 °C, aby sa zabránilo rastu baktérií.
- Zabezpečenie správneho prietoku a cirkulácie vody vo vodovodných systémoch s cieľom minimalizovať riziko hromadenia stojatej vody.
- Dezinfekcia vrchných vodovodných systémov vyšším obsahom chlóru (50 mg/l) počas 2 - 4 hodín po ukončení akýchkoľvek prác na systéme a pred začiatkom každej vykurovacej sezóny.
Odběr vzoriek na testy Legionella
1) Pri odbere vzoriek vody na testovanie Legionelly je dôležité dodržiavať určité požiadavky, aby sa zabezpečilo presné a spoľahlivé vyhodnotenie výsledkov.
2) Miesta odberu vzoriek: Identifikujte a vyberte vhodné miesta odberu vzoriek v rámci vodovodného systému, pričom sa zamerajte predovšetkým na miesta s vyšším rizikom kontaminácie, ako je definované vyššie. Laboratóriá ALS poskytujú profesionálny a akreditovaný odber vzoriek.
3) Vzorkovnice na vzorky: používajte len sterilné vzorkovnice ALS, ktoré sú určené na odber vzoriek vody na testovanie na Legionellu. Tieto vzorkovnice na vzorky sú špeciálne navrhnuté tak, aby chránili vzorku a zabránili jej kontaminácii počas prepravy do laboratória. Vzorkovnicu naplňte len po požadovanú úroveň.

4) Technika odberu vzoriek: správna metóda odberu vzoriek je dôležitá, aby sa zabránilo nežiaducej kontaminácii. Používajte rukavice, nechajte vodu krátko samovoľne odtekať a naplňte vzorkovnicu po vyznačenú hladinu. Pri odbere zmerajte aj teplotu vody.
5) Preprava vzoriek: Po odbere by sa vzorky mali uchovávať v chlade (5+/-3 °C), ale nie zmrazené. Vzorky doručte do laboratória čo najskôr; do prepravného kontajnera by mali byť vložené obaly s ľadom. Vzorky musia byť doručené do laboratória alebo pobočky do 24 hodín. Holding time (čas, v ktorom sa musí začať analýza) je 48 hodín od odberu vzorky na analýzu Legionelly.
6) Výsledky: Vzhľadom na to, že čas spracovania vzoriek a samotnej inkubácie je 10 dní, čas vyreportovania výsledkov je približne 12 dní.
7) Frekvencia odberu vzoriek: pravidelný odber vzoriek a analýza sú nevyhnutné, najmä v prostredí s vyšším rizikom. Stanovenie harmonogramu pravidelného odberu vzoriek by sa malo určiť na miestnej úrovni na základe posúdenia rizika vodného systému.
Literatúra:
- Legionnaires‘ disease. Annual Epidemiologial Report for 2021.
https://www.ecdc.europa.eu/sites/default/files/documents/legionnaires- disease-annual-epidemiological-report-2021.pdf - Directive (EU) 2020/2184 of the European Parliament and of the Council of 16 December 2020 on the quality of water intended for human consumption.
- Legionella water testing and the EU Drinking Water Directive: could potentially harmful Legionella bacteria slip through the gaps? S. Delaney, T. Arcari, O. O´Connor. BioTechniques, 2022. https://doi.org/10.2144/btn-2022-0047


